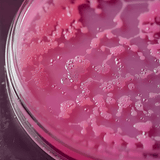

NUTRiHERBS L-Glutathione
NUTRiHERBS L-Glutathione supports your body's natural defense system, promote radiant skin, and enhance overall wellness. Infused with a potent combination of L-Glutathione, Vitamin C, Vitamin E, L-Lysine, Grape Seed Extract, and Biotin, this formula can provide comprehensive antioxidant support to help you achieve a robust immune system and youthful complexion.
What is L-Glutathione and how does it work?
L-Glutathione is a powerful antioxidant found naturally in the body. It helps neutralize free radicals, supports liver detoxification, and promotes healthy skin by reducing the appearance of blemishes and improving complexion.
Key Benefits of NUTRiHERBS L-Glutathione:
At NUTRiHERBS, we utilize L-Glutathione in this supplement while adding in other vitamins and nutrients, such as Vitamin C, Vitamin E, L-Lysine, Grape Seed Extract, and Biotin, to make this blend more effective for wellness. Here’s how they all work together:
- Radiant Skin: L-Glutathione is known for its powerful ability to neutralize free radicals, reduce the appearance of blemishes, and promote a glowing complexion.
- Immune Health: With the addition of Vitamin C and Vitamin E, this formula helps boost your overall health, fight off oxidative stress, and maintain overall health.
- Hair & Nails: The inclusion of Biotin and L-Lysine aids in supporting strong, healthy hair and nails, ensuring you look your best from head to toe.
- Antioxidant Powerhouse: Grape Seed Extract enhances the formula with its potent antioxidant properties, helping to protect cells from damage and support cardiovascular health.
- Enhanced Absorption: Our unique blend is designed for maximum absorption, ensuring that your body can efficiently utilize these essential nutrients.


Vitamin C

Vitamin E

L-Glutathione Root

L-Lysine

Grape Seed Extract

Biotin

Vitamin C

Vitamin E

L-Glutathione Root
L-Lysine

Grape Seed Extract

Biotin
How to Use L-Glutathione
Take 1 capsule daily, preferably with a meal, or as directed by your healthcare professional.
Ingredients:
- L-Glutathione (500 mg): A powerful antioxidant that may support skin health, detoxification, and immune function.
- Vitamin C (40 mg): Essential for collagen production and immune support, it can enhance the effectiveness of L-Glutathione.
- Vitamin E (10 mg): Can protect cells from oxidative damage and may support skin health.
- L-Lysine (150 mg): An essential amino acid that can promote healthy skin and aids in collagen formation.
- Grape Seed Extract (100 mg): Rich in antioxidants, it may aid in protecting against free radical damage and promotes cardiovascular health.
- Biotin (0.03 mg): Can supports healthy hair, skin, and nails, promoting a vibrant appearance.

Results will vary among consumers, but many users notice improvements in their skin's radiance and overall well-being within 4-8 weeks of consistent use.
Yes, NUTRiHERBS L-Glutathione Complex can be taken alongside other supplements. However, we recommend consulting with your healthcare provider to ensure optimal compatibility.
NUTRiHERBS L-Glutathione Complex is free from common allergens such as gluten, dairy, and soy. It is also non-GMO and vegan.